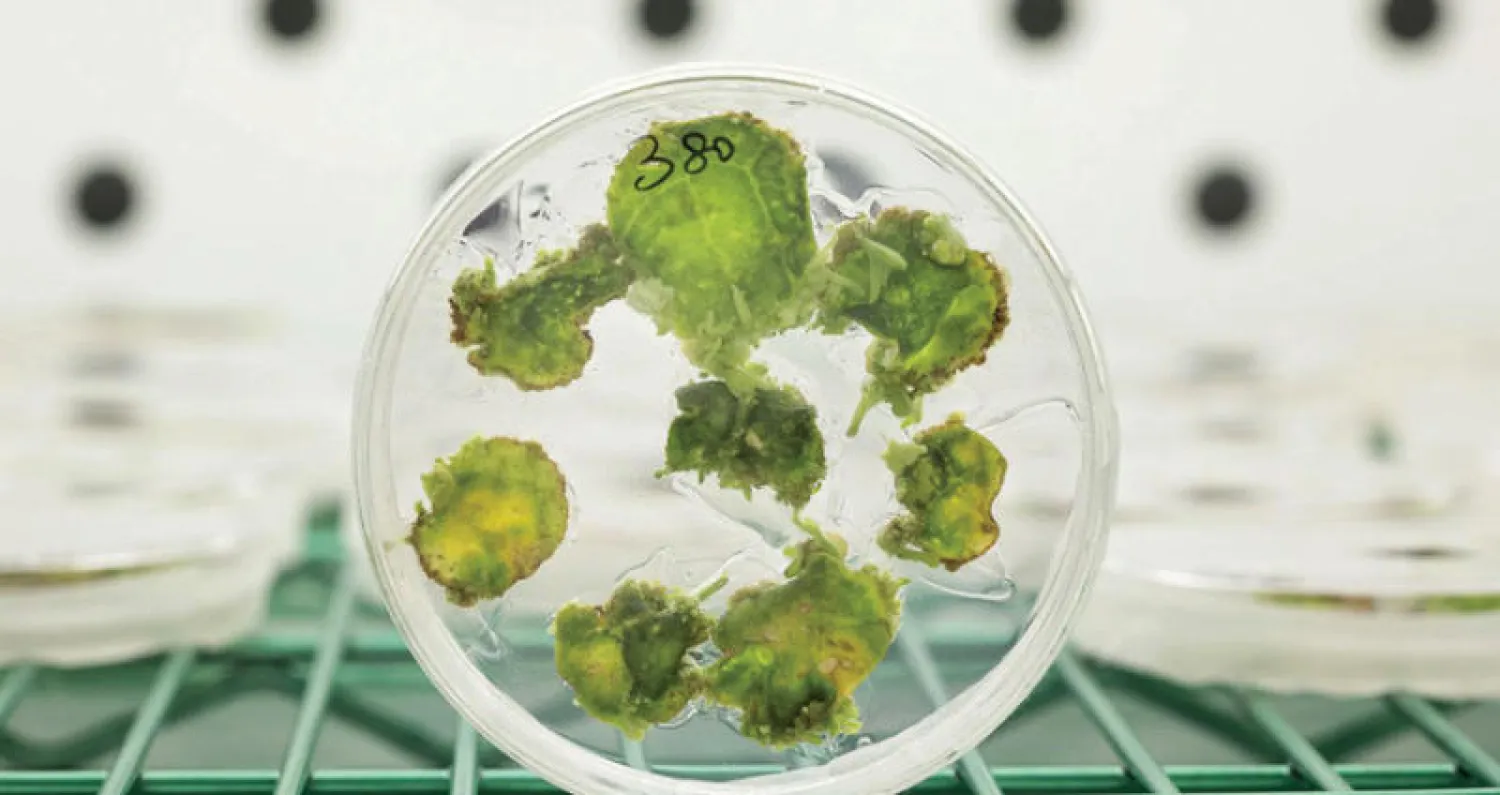
الجوع المعتدل مفيد للصحة ويقلل من مخاطر الأمراض

يغير الجوع المعتدل عملية التمثيل الغذائي ويؤثر في الإيقاع اليومي، ما يؤدي إلى تحسن الصحة وتقليل مخاطر الأمراض المرتبطة بالشيخوخة، حسبما ذكر علماء من جامعة كاليفورنيا في إرفاين.
وتشير الدراسة إلى أن الجوع يؤثر في الإيقاع اليومي للساعة الداخلية للجسم، التي تنظم معظم عمليات التمثيل الغذائي والإنتاج الهرموني من أجل تنظيم نشاط كل خلية، حسبما ذكر الباحثون في تقرير «المقالة في مجلة (Cell Reports)».
كما أجريت دراسة على الفئران المخبرية التي لم تتناول أي طعام خلال 24 ساعة. ولاحظ الباحثون أن الفئران الجائعة كانت تستهلك كمية قليلة من الأكسجين والطاقة. كما انخفضت النسبة بين ثاني أكسيد الكربون في الزفير والأكسجين المستنشق، وعندما أطعموها، اختفت جميع هذه الملاحظات، حسبما ذكرته «نوفوستي».
وأشار الباحثون إلى أن الجوع يؤثر في عمل الجينات والبروتينات الأساسية للإيقاع اليومين، فقد اتضح لهم انخفاض نشاط بروتينات «BMAL» و«REV - ERBa» التي تحدد العمل اليومي للكبد والعضلات الهيكلية.
وعلق البروفسور باولو ساسوني - كورسي، من المدرسة الطبية (UCI)، قائلاً: «يعمل الجوع على إعادة برمجة سلسلة من التفاعلات الخلوية، ما ينعكس إيجاباً على الصحة، ويثبط تطور الأمراض والشيخوخة».
8:33 دقيقه
الجوع المعتدل مفيد للصحة ويقلل من مخاطر الأمراض
https://aawsat.com/home/article/1554331/%D8%A7%D9%84%D8%AC%D9%88%D8%B9-%D8%A7%D9%84%D9%85%D8%B9%D8%AA%D8%AF%D9%84-%D9%85%D9%81%D9%8A%D8%AF-%D9%84%D9%84%D8%B5%D8%AD%D8%A9-%D9%88%D9%8A%D9%82%D9%84%D9%84-%D9%85%D9%86-%D9%85%D8%AE%D8%A7%D8%B7%D8%B1-%D8%A7%D9%84%D8%A3%D9%85%D8%B1%D8%A7%D8%B6



الجوع المعتدل مفيد للصحة ويقلل من مخاطر الأمراض


الجوع المعتدل مفيد للصحة ويقلل من مخاطر الأمراض
مواضيع
لم تشترك بعد
انشئ حساباً خاصاً بك لتحصل على أخبار مخصصة لك ولتتمتع بخاصية حفظ المقالات وتتلقى نشراتنا البريدية المتنوعة









